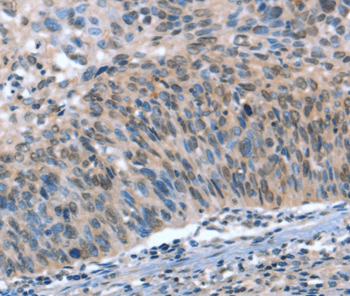

Immunohistochemical staining of human cerebellum shows weak to moderate nuclear positivity in cells in molecular layer.
Anti-CAMTA1 Antibody
HPA036343
ApplicationsImmunoCytoChemistry, ImmunoHistoChemistry
Product group Antibodies
ReactivityHuman
TargetCAMTA1
Overview
- SupplierAtlas Antibodies
- Product NameAnti-CAMTA1 Antibody
- Delivery Days Customer4
- ApplicationsImmunoCytoChemistry, ImmunoHistoChemistry
- CertificationResearch Use Only
- ClonalityPolyclonal
- ConjugateUnconjugated
- Gene ID23261
- Target nameCAMTA1
- Target descriptioncalmodulin binding transcription activator 1
- Target synonymsCANPMR, CECBA, calmodulin-binding transcription activator 1
- HostRabbit
- IsotypeIgG
- Protein IDQ9Y6Y1
- Protein NameCalmodulin-binding transcription activator 1
- Scientific DescriptionRecombinant Protein Epitope Signature Tag (PrEST) antigen sequence
- ReactivityHuman
- Storage Instruction-20°C,2°C to 8°C
- UNSPSC41116161